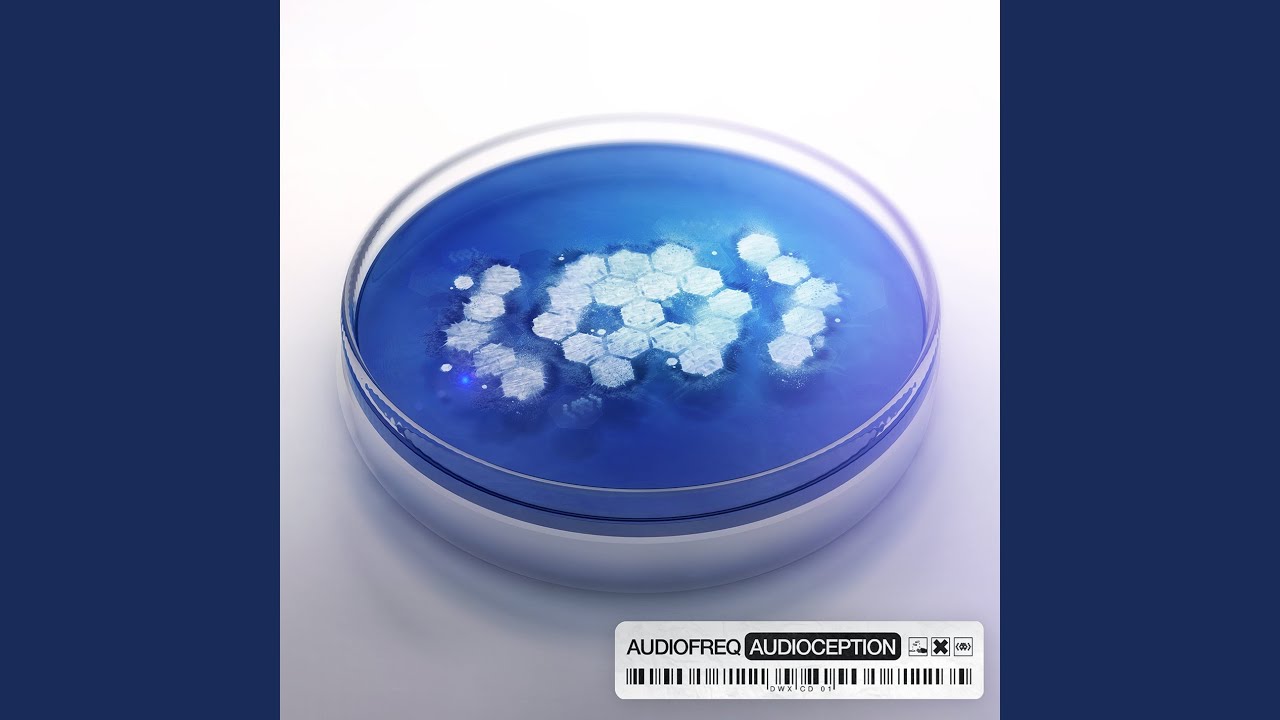
Speekaz Kikk (Extended Version)

Последние добавленные видео:
Audioception
-
 1052 1:17:43
1052 1:17:43Audioception (Full Album Mix)
-
 12 лет назад
32751 12 лет назад 1:17:47
12 лет назад
32751 12 лет назад 1:17:47Audiofreq - Audioception (Accelerate Your Evolution)
-
 12 лет назад
16688 12 лет назад 5:10
12 лет назад
16688 12 лет назад 5:10Audiofreq - Audioception Part 2 (Official HQ Preview)
-
 12 лет назад
23097 12 лет назад 1:40
12 лет назад
23097 12 лет назад 1:40Accelerate your evolution with AUDIOCEPTION (An Audiofreq commercial)
-
 12 лет назад
605 12 лет назад 48:37
12 лет назад
605 12 лет назад 48:37Audiofreq - Audioception (Album mix)
-
 8703 5:46
8703 5:46Chase (Extended Version)
-
![Audiofreq ft. Teddy - Chase (Audioception) [04]](https://imager.clipsaver.ru/OpCVzawkmOw/max.jpg) 12 лет назад
1616 12 лет назад 5:46
12 лет назад
1616 12 лет назад 5:46Audiofreq ft. Teddy - Chase (Audioception) [04]
-
 1286 4:34
1286 4:34Caged (Extended Version)
-
![Audiofreq ft. Teddy - Caged (Audioception) [14]](https://imager.clipsaver.ru/C8CECtzyj9Q/max.jpg) 12 лет назад
6302 12 лет назад 4:34
12 лет назад
6302 12 лет назад 4:34Audiofreq ft. Teddy - Caged (Audioception) [14]
-
 1338 4:55
1338 4:55Volition (Extended Version)
-
![Audiofreq - Volition (Audioception) [09]](https://imager.clipsaver.ru/dERlxU3KXHY/max.jpg) 12 лет назад
4666 12 лет назад 4:55
12 лет назад
4666 12 лет назад 4:55Audiofreq - Volition (Audioception) [09]
-
602 5:38
602 5:38Speekaz Kikk (Extended Version)
-
![Audiofreq ft. MC Shureshock - Speekaz Kikk (Audioception) [07]](https://imager.clipsaver.ru/8zIqstgYFKM/max.jpg) 12 лет назад
1734 12 лет назад 5:34
12 лет назад
1734 12 лет назад 5:34Audiofreq ft. MC Shureshock - Speekaz Kikk (Audioception) [07]